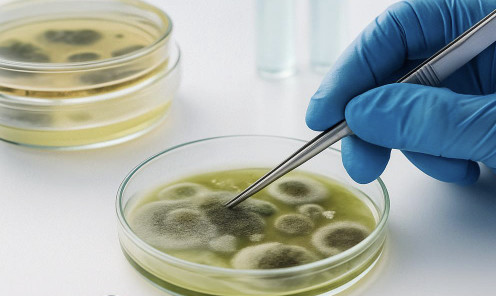

At NorCal Mold & Air, we provide thorough mold and air quality inspections for both residential and commercial properties, helping identify and quantify airborne health risks such as mold, allergens, and other indoor pollutants. Our detailed reports empower property owners, buyers, renters and managers to make informed decisions that protect their real estate and promote healthier living and working environments. With every inspection, we’re proud to support a safer, cleaner community and a better quality of life.

Protect your home and loved ones with our detailed inspections that detect mold, allergens, and indoor air pollutants. We help homeowners, buyers, and renters create safer, healthier living environments tailored for properties up to 4 units. Our residential mold inspections start at $249

Ensure a clean and compliant environment with our expert inspections tailored for offices, retail spaces, industrial buildings, restaurants, and apartment buildings. We identify airborne health risks to support employee, client, and tenant wellness and operational integrity. Our commercial mold inspections start at $499

Early Detection
Identify mold and saturation issues before they spread, saving time and money on remediation.

Improved Health
Reduce allergens and toxins that may be affecting your respiratory health.

Accurate results
Certified lab analysis ensures precise identification of mold types and levels.

Peace of Mind
Confirm whether your property is safe or requires remediation.

Property Protection
Prevent mold damage from depreciating your property’s worth.

Customized Solutions
Receive tailored recommendations based on test results.

Mold Identification
Mold identification through tape or swab sampling involves collecting surface samples from suspected areas of mold growth. These samples are then analyzed in a laboratory to determine the type and concentration of mold present. This method helps confirm visual findings and assess potential health risks based on mold species.

Airborne Spore Count
Airborne spore count during air sampling measures the concentration of mold spores present in the indoor air. Using specialized equipment, our inspectors collect air samples that are analyzed in a lab to identify mold types and quantify spore levels. This helps determine if indoor air quality is compromised and whether mold growth may be occurring out of sight.
ERMI Testing
Environmental Relative Moldiness Index testing uses advanced DNA-based analysis to assess mold contamination in indoor environments. Dust samples are collected from surfaces and analyzed for the presence of 36 mold species, providing a detailed mold profile and a numerical score that indicates the relative moldiness of the space. This method helps our inspectors and clients understand hidden mold risks and make informed decisions about remediation.

Environmental Testing
Environmental testing for mold includes using tools like humidity meters to measure indoor moisture levels and moisture meters to detect dampness within building materials. Infrared cameras and infrared thermometers help identify temperature variations that may indicate hidden moisture or water intrusion behind walls or ceilings. These readings help our inspectors locate areas at risk for mold growth even when no visible signs are present.

Allergen Testing
Allergen testing evaluates indoor environments for airborne particles like pollen, dust mites, pet dander, and mold spores that can trigger allergic reactions. Our inspectors collect air or dust samples and send them to a lab for analysis to identify and quantify specific allergens. This helps determine if the space poses health risks and guides steps to improve air quality.
At NorCal Mold & Air, we follow a proven, detailed process to ensure the most accurate mold and air quality testing results.
Our four-step approach ensures that every issue is thoroughly identified, documented, and addressed.
1. Visual Inspection

Examination: We perform a thorough visual inspection of the property, including basements, attics, HVAC, bathrooms, and areas around plumbing fixtures.
Identification: We look for visible mold growth, signs of water damage, and environmental conditions conducive to mold.
Documentation: We capture high-quality photos to visually support our findings.
Education: We inform clients about areas of concern and potential causes of mold development.
2. Sample Collection

Technology: We use advanced tools like moisture meters, infrared cameras, and borescopes to detect hidden mold and moisture sources
Sample Collection: We take air and surface samples from different areas of the property to capture mold spores present in the indoor environment.
Extent Evaluation: We assess the size, spread, and severity of mold contamination to determine risk levels.
Laboratory Submission: We send all samples to accredited labs for professional analysis.
3. Laboratory Analysis

Analysis: Laboratories identify the types of mold present, their concentration levels, and potential health impacts.
Reporting: We compile a comprehensive report detailing both visual and laboratory findings.
Interpretation: We clearly explain what the lab results mean in terms of air quality, mold species, and potential hazards.
Compliance: All documentation meets regulatory and industry standards for thorough, defensible reporting.
4. Reporting & Recommendations

Remediation Guidance: We provide personalized recommendations for mold remediation and moisture control strategies.
Referrals: We offer referrals to licensed, vetted mold remediation professionals.
Verification: We conduct a thorough post-remediation inspection to verify that mold removal was successful and that the environment is safe.
Ongoing Support: We assist clients with follow-up questions, guidance during remediation, and future assessments as needed.
We are committed to offering top-notch mold and air inspections for both residential & commercial properties. Our team ensures you make informed decisions, providing thorough and reliable reports. Whether you’re buying, selling, renting, or maintaining a property, trust us to be your partner every step of the way.
© NorCal Mold & Air 2025. All Rights Reserved.